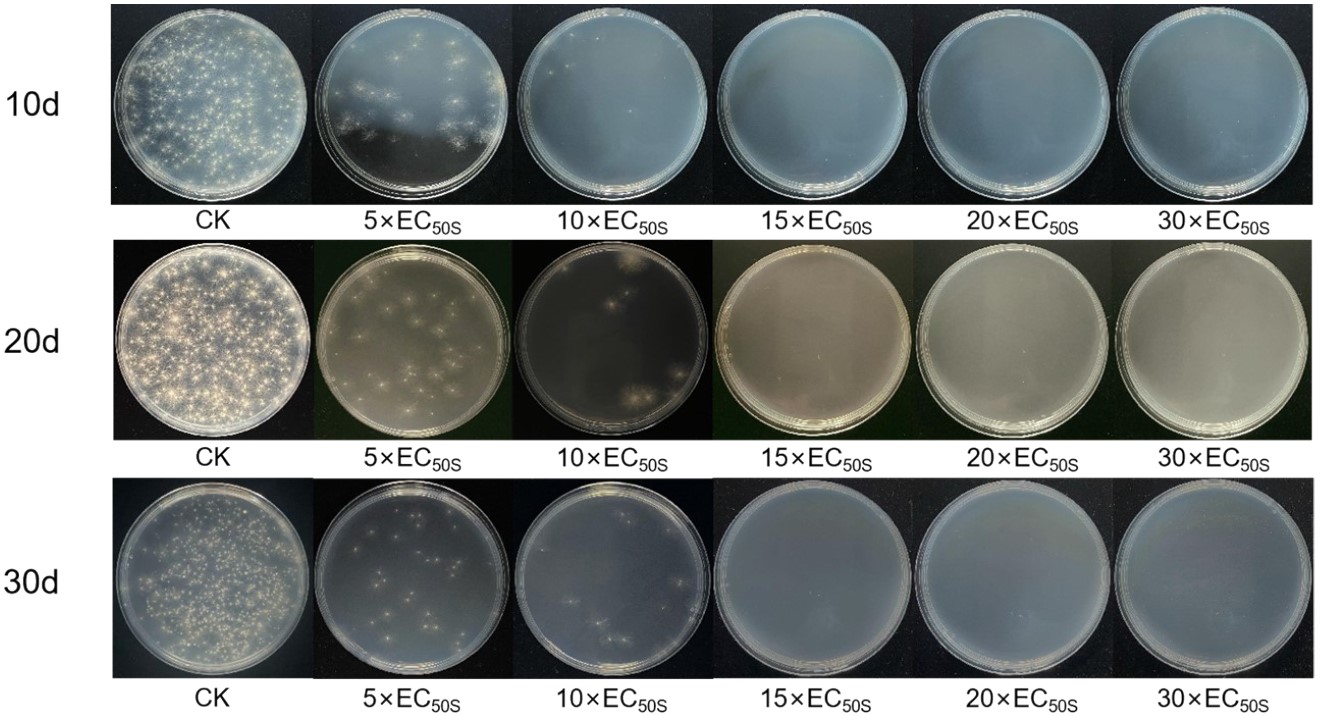

Las sales de polimetacrilato de guanidina suprime los hongos fitopatógenos del suelo, caso Foc R4T
Se investigó que las sales de polimetacrilato de guanidina inhiben Foc R4T en el suelo de manera efectiva y selectiva, Se observó que presentaron un impacto mínimo en los microorganismos nativos y que tienen la ventaja de adsorberse en el suelo, lo que permite una liberación controlada manteniendo el efecto antifungico hasta por 30 días y que reducen su liberación al medio ambiente. Podría ser una opción económica, segura y sostenible contra enfermedades del suelo como Foc R4T.
- Más información en: pubs.rsc.org
Noticias similares
-

Nigrospora oryzae, un nuevo patógeno en soya que causa la pudrición radicular en China
De muestras de campos de soya con síntomas de pudrición de raíz se obtuvieron y validaron más...
-

Primer reporte de Phytophthora sansomeana que causa pudrición radicular de la soya en Dakota del Norte, EE.UU.
Se recolectaron muestras de suelo de campos de soya que presentaban síntomas de pudrición de la...
-

Primer reporte de Fusarium oxysporum f. sp. cubense Raza 4 Tropical (VCG 01213/16) causante de marchitamiento por Fusarium en banano en Nepal
En bananos Cavendish cv. Grand Naine, se observaron síntomas típicos de marchitamiento por...






